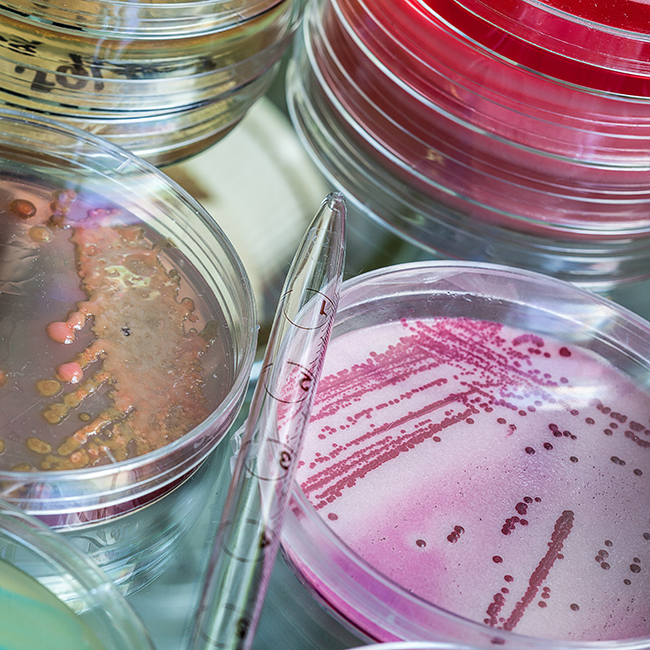

Legionella risk assessments
What is a legionella risk assessment?
A Legionella risk assessment is carried out by a trained professional and identifies non-compliances that increase the risk of legionella bacteria. The assessment informs the measures you need to maintain water safety at your organisation.
Legionella risk assessments are a legal obligation of every organisation with a water system. The assessments limit the risk of employees and customers contracting the potentially fatal Legionnaire’s disease from water vapour.
A suitable and sufficient Legionella Risk Assessment must be carried out to identify and assess the risk of exposure from water systems on your premises, as stated by the Approved Code of Practice (ACoP) L8.

Book a legionella risk assessment for your business
Use the form to get in touch with our team and we'll guide you through the process.
Who should arrange Legionella water testing?
Every business or organisation needs to conduct a regular risk assessment including water testing. The ‘duty holder’ is responsible for making sure the risk assessment is arranged and carried out.
The person responsible will usually be one of the following:
- the employer, where the risk from their undertaking is to their employees or others
- a self-employed person, where there is a risk from their undertaking to themselves or others
- the person in control of premises or systems in connection with work, where there is a risk from systems in the building e.g. where a building is let to tenants and the landlord keeps responsibility for its maintenance.
Premises that have hot and cold-water systems, cooling systems, showers spa pools, or plant that contain water all carry reasonable risk of Legionella.
Your responsibility for compliant Legionnaire’s testing
You must ensure the Legionella risk assessment identifies and evaluates potential sources of risk. The risk assessment must be reviewed regularly and specifically when there is reason to believe that the original risk assessment may no longer be valid.
Put simply, it involves a qualified plumbing engineer assessing your water system, water quality, and treatment processes. We test the water for the presence of Legionella bacteria and look at how water is stored and used.
Our risk assessment is offered as a standalone service or we can offer a range of complementary services including Legionella monitoring, remedial works, and cleaning and disinfection. Our Legionella risk assessments are carried out in-line with ACoP L8, BS: 8580 & HTM 04-01.
Do you have a question about legionnaires testing or Legionella risk assessments for your business? Get in touch with our team and we’ll guide you through the process.
